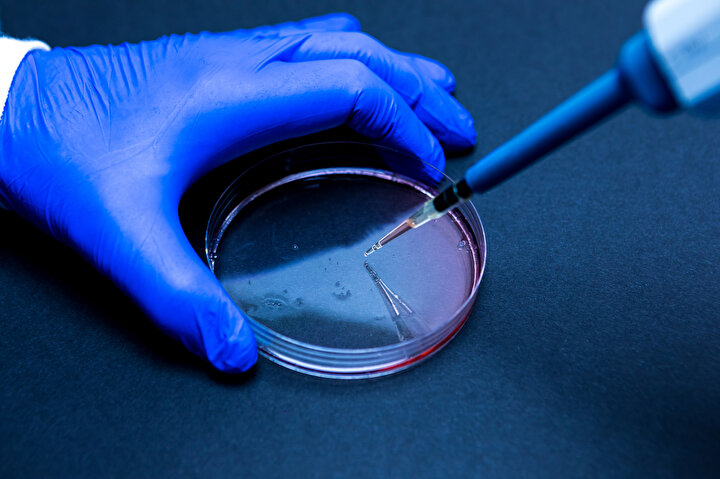
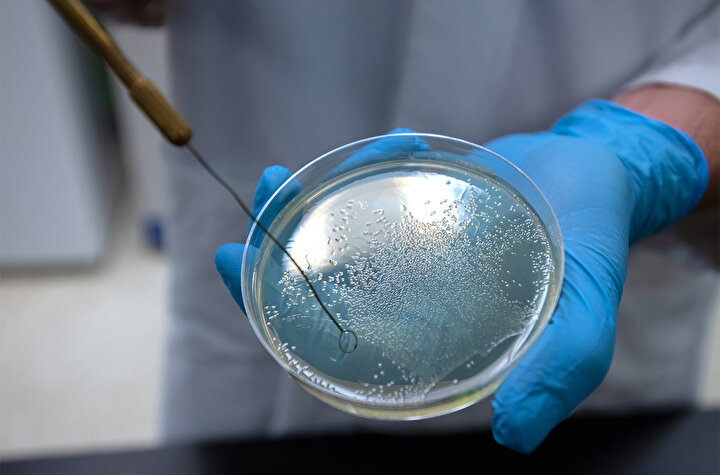

Yaz mevsimiyle birlikte tatil keyifleri başladı, ancak uzmanlar önemli bir konuda uyarıyor: Sıcaklıkların artmasıyla birlikte bazı zararlı bakteriler deniz suyunda daha fazla görülmeye başladı. Özellikle açık yarayla denize girenlerde ciddi bir enfeksiyon riski söz konusu. Türkiye kıyılarında yapılan son gözlemler, bu konunun ciddiyetini bir kez daha gözler önüne serdi. Peki, bu bakterilerden nasıl korunabiliriz? İşte detaylar.

Uzmanlar, yaz aylarıyla beraber deniz ve havuzlarda bazı bakteriyel risklerin artabileceğine dikkat çekiyor. Özellikle ciltte kesik ya da yara bulunanların dikkatli olması öneriliyor. Marmara, Ege ve Akdeniz kıyılarında da tespit edilen bazı bakteri türlerinin ardından uzmanlardan uyarılar peş peşe geldi.

🌊 PLAJLARDA TEHLİKE: “VİBRİO” BAKTERİSİ
Küresel ısınma sadece hava sıcaklıklarını değil, denizleri de etkiliyor. Suyun ısınmasıyla birlikte zararsız gibi görünen deniz ortamı, ölümcül mikroorganizmalar için ideal bir yaşam alanına dönüşüyor. Avrupa Hastalık Önleme ve Kontrol Merkezi (ECDC), geçtiğimiz yıllarda yalnızca Baltık Denizi’nde rastlanan Vibrio bakterilerinin artık Kuzey Denizi ve kapalı yüzme alanlarında da görüldüğünü açıkladı.

📍 TÜRKİYE KIYILARINDA DA TESPİT EDİLDİ
Tehlike artık Türkiye’de de kapıda. Milliyet'te yer alan habere göre; son dönemde yapılan bilimsel çalışmalarda, Marmara, Ege ve Akdeniz kıyılarında “Vibrio parahaemolyticus” ve “Vibrio vulnificus” gibi bakterilerin DNA izlerine rastlandı. İstanbul Florence Nightingale Hastanesi’nden Üroloji Uzmanı Op. Dr. Uğur Aferin, özellikle yaz aylarında denize giren kişilerin dikkatli olması gerektiğini vurguladı.
🦠 AÇIK YARADAN GİRİP ENFEKSİYONA NEDEN OLUYOR
Dr. Aferin, Vibrio bakterilerinin sıcak ve tuzlu suları sevdiğini belirterek, özellikle “Vibrio cholerae” türünün kirli deniz suyunun yutulmasıyla mide-bağırsak sistemine girip şiddetli ishal ve sıvı kaybına yol açabileceğini aktardı. Türkiye’de kolera vakası nadir görülse de, sıfır riskin söz konusu olmadığını belirtti.

⚠️ “ET YİYEN BAKTERİ” OLARAK BİLİNİYOR
Vibrio bakterilerinin asıl riskinin açık yaralardan vücuda girmesiyle başladığını dile getiren Dr. Aferin, “Vibrio vulnificus, deride ciddi doku enfeksiyonlarına neden olabilir. Hatta nadiren de olsa, halk arasında ‘et yiyen bakteri’ olarak bilinen nekrotizan fasiit gibi ölümcül sonuçlara yol açabilir,” ifadelerini kullandı.
🍽️ ÇİĞ DENİZ ÜRÜNLERİNDEN BULAŞABİLİR
Vibrio parahaemolyticus türü ise genellikle çiğ deniz ürünleri, özellikle çiğ istiridye tüketimiyle bulaşıyor. Bu tür enfeksiyonlar karın ağrısı, ateş, kusma ve ishal gibi belirtilerle kendini gösterebiliyor. Bağışıklık sistemi zayıf bireylerde ise enfeksiyon kana karışarak sepsise dönüşme riski taşıyor.

🚺 ISLAK MAYO VE İDRAR YOLU ENFEKSİYONU
Dr. Aferin, yaz aylarında özellikle kadınların uzun süre ıslak mayo ile kalmamaları gerektiğini vurguladı. Nemli ve sıcak ortam, bakteriler için uygun bir zemin hazırlıyor. Özellikle E. coli gibi bakteriler bu koşullarda idrar yollarına ulaşarak enfeksiyona neden olabiliyor. İdrar yapma ihtiyacının ertelenmemesi, enfeksiyon riskini azaltmak için önemli.

🏊 HAVUZLARDAKİ TEHLİKELERE DİKKAT
Sadece deniz değil, havuzlar da risk barındırıyor. Özellikle yeterince temizlenmeyen havuzlarda rotavirüs, hepatit A, salmonella ve ekoli gibi bakterilere rastlanabiliyor. Çocuk Sağlığı ve Hastalıkları Uzmanı Dr. Hüseyin Yıldız, 4. aydan önce bebeklerin denize, 6. aydan önce ise havuza sokulmamasını öneriyor. Bu dönemdeki bebeklerde ısı ve sıvı kaybı ciddi sonuçlar doğurabilir.

📌 VİBRİO BAKTERİSİ EN ÇOK NEREDE GÖRÜLÜYOR?
Marmara, Ege ve Akdeniz sahilleri
Sıcak, tuzlu ve düşük tuzluluk oranına sahip sular
Kapalı, sıcak ve sirkülasyonu düşük yüzme alanları
🚫 NASIL BULAŞIYOR?
Açık yaraların denizle teması
Kirli deniz suyunun yutulması
Çiğ deniz ürünlerinin tüketimi

❗ BU BELİRTİLERE DİKKAT!
Ani gelişen ishal
Ateş ve kusma
Ciltte kızarıklık, ödem
Doku enfeksiyonu ve sepsis riski
✅ KORUNMAK İÇİN NELER YAPILMALI?
Denize girdikten sonra mutlaka duş alın
Islak mayo ile uzun süre kalmayın
Açık yaraları su geçirmez bant ile kapatın
Çiğ deniz ürünlerinden uzak durun
İdrar yapma ihtiyacını ertelemeyin






